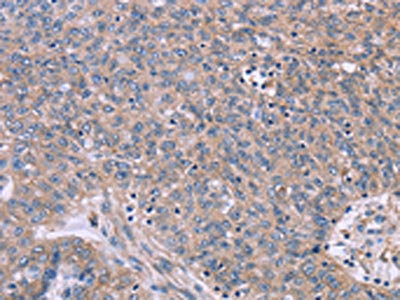

CSF2RB Antibody
-
中文名稱:CSF2RB兔多克隆抗體
-
貨號:CSB-PA200894
-
規格:¥1100
-
圖片:
-
The image on the left is immunohistochemistry of paraffin-embedded Human cervical cancer tissue using CSB-PA200894(CSF2RB Antibody) at dilution 1/40, on the right is treated with synthetic peptide. (Original magnification: ×200)
-
The image on the left is immunohistochemistry of paraffin-embedded Human ovarian cancer tissue using CSB-PA200894(CSF2RB Antibody) at dilution 1/40, on the right is treated with synthetic peptide. (Original magnification: ×200)
-
-
其他:
產品詳情
-
Uniprot No.:
-
基因名:
-
別名:Beta-C antibody; CD131 antibody; CDw131 antibody; Colony stimulating factor 2 receptor beta antibody; Colony stimulating factor 2 receptor beta low affinity (granulocyte macrophage) antibody; Common beta chain antibody; Csf2rb antibody; Cytokine receptor common beta chain antibody; Cytokine receptor common beta chain precursor (CDw131 antigen) antibody; Cytokine receptor common subunit beta antibody; GM CSF/IL 3/IL 5 receptor common beta chain antibody; GM-CSF/IL-3/IL-5 receptor common beta subunit antibody; granulocyte-macrophage colony-stimulating factor receptor, beta antibody; IL3RB antibody; IL3RB_HUMAN antibody; IL5RB antibody; Interleukin 3 receptor, beta antibody; Interleukin 3 receptor/granulocyte macrophage colony stimulating factor 3 receptor beta (high affinity) antibody; Interleukin 5 receptor, beta antibody; SMDP5 antibody; stimulating factor 3 receptor, beta (high affinity) antibody
-
宿主:Rabbit
-
反應種屬:Human
-
免疫原:Synthetic peptide of Human CSF2RB
-
免疫原種屬:Homo sapiens (Human)
-
標記方式:Non-conjugated
-
抗體亞型:IgG
-
純化方式:Antigen affinity purification
-
濃度:It differs from different batches. Please contact us to confirm it.
-
保存緩沖液:-20°C, pH7.4 PBS, 0.05% NaN3, 40% Glycerol
-
產品提供形式:Liquid
-
應用范圍:ELISA,IHC
-
推薦稀釋比:
Application Recommended Dilution ELISA 1:2000-1:5000 IHC 1:50-1:200 -
Protocols:
-
儲存條件:Upon receipt, store at -20°C or -80°C. Avoid repeated freeze.
-
貨期:Basically, we can dispatch the products out in 1-3 working days after receiving your orders. Delivery time maybe differs from different purchasing way or location, please kindly consult your local distributors for specific delivery time.
-
用途:For Research Use Only. Not for use in diagnostic or therapeutic procedures.
相關產品
靶點詳情
-
功能:High affinity receptor for interleukin-3, interleukin-5 and granulocyte-macrophage colony-stimulating factor.
-
基因功能參考文獻:
- SYK mediates the actions of EPO and GM-CSF and coordinates with TGF-beta in erythropoiesis. PMID: 28131718
- Exome sequencing identified candidate variants, including a missense mutation in DUOX2 that impaired its function and a frameshift mutation in CSF2RB that was associated with Crohn's Disease in an independent cohort of Ashkenazi Jewish individuals. PMID: 27373512
- In a genetic analysis of Ashkenazi Jewish individuals, we associated Crohn's Disease with a frameshift mutation in CSF2RB. Intestinal monocytes from carriers of this mutation had reduced responses to granulocyte-macrophage colony-stimulating factor, providing an additional mechanism for alterations to the innate immune response in individuals with Crohn's Disease. PMID: 27377463
- VitD-mediated stimulation of GC anti-inflammatory affects human monocytes in a process involving GM-CSF and MED14 PMID: 23572530
- These data suggest that expression of GM-CSF and its receptor subunits by colon tumors may be a useful marker for prognosis PMID: 23108143
- JAK kinase binding to betac requires the presence of three critical betac lysine residues, and this binding event is essential for receptor ubiquitination, endocytosis, and signaling. PMID: 21965659
- Over expression of IL-3Ralpha and truncated mutation of hbetac may be involved in proliferation and differentiation block in NB4 cells. PMID: 21176354
- Granulocyte/macrophage colony-stimulating factor causes a paradoxical increase in the BH3-only pro-apoptotic protein Bim in human neutrophils PMID: 20705940
- The results of the study support CSF2RB as a risk factor common to both schizophrenia and major depression in the Chinese Han population. PMID: 21247258
- Hereditary pulmonary alveolar proteinosis caused by recessive CSF2RB mutations [case report] PMID: 21205713
- the up-regulation of IL-3Rbeta expression may contribute to the maintenance of proliferation rather than cell differentiation. PMID: 21207215
- The beta1 integrin-interacting domain in the extracellular domain of IL-3Rbeta was identified. A fragment of a protein corresponding to domain 4 of IL-3Rbeta prevented IL-3-mediated arterial morphogenesis and endothelial cell migration. PMID: 20802515
- the domain 1 D-E loop disulfide of hbetac and beta(IL-3) have roles in maintaining the precise positions of ligand-binding residues necessary for normal high affinity binding and signaling PMID: 20516062
- Two different modes of beta c binding are utilized in the presence of the hIL-3R alpha isoforms. PMID: 20472554
- hGM-CSF activation of hGM/beta(c)with or w/o the hbeta(c) subunit, promoted primitive phenotype maintenance, indicating that the hGM Ralpha chain cytosolic domain is needed for differentiation mediated by the hGM Ralpha, beta(c) receptor complex. PMID: 12384414
- JAK2 activation mediates cross-talk between extracellular domain mutants of the beta-subunit of the GM-CSF receptor and EpoR PMID: 12488507
- Interleukin-3 binding to the human betac receptor involves functional epitopes formed by domains 1 and 4 of different protein chains PMID: 15060062
- A minor improvement in resolution has given a clearer indication of the position and stabilization of the key residues Tyr15, Phe79, Tyr347, His349, Ile350 and Tyr403 in the elbow region between domain 1 and domain 4 of the dimer-related molecule. PMID: 16754968
- These results suggest that the JAK1-JH7-3 domains are required for interleukin-3 receptor common beta subunit interaction and abolish wild type JAK1 and JAK2-mediated signaling. PMID: 16767694
- This study found that several markers (rs2072707, rs2284031 and rs909486)of csf2rb showed sex-specific and family history-dependent associations with schizophrenia. PMID: 17667962
- The dynamic role of the common signaling subunit beta c is to prevent IL5alpha and GM-CSF ligand-receptor complexes from rapidly dissociating. PMID: 18294864
- The interaction between intercellular adhesion molecule 1 (ICAM-1) and the GM-CSF receptor is essential for GM-CSF-induced eosinophil activation and survival. PMID: 18322230
- IL-5-induced effects on betac assembly in the presence of nontagged IL-5Ralpha provide direct evidence that IL-5 can cause higher order rearrangements of betac homo-oligomers PMID: 18326494
- Ligand-binding and receptor activation are not critically dependent on individual N-glycosylation sites within the IL-3- and IL-5-receptor common beta-subunit. PMID: 18374598
顯示更多
收起更多
-
相關疾病:Pulmonary surfactant metabolism dysfunction 5 (SMDP5)
-
亞細胞定位:Membrane; Single-pass type I membrane protein.
-
蛋白家族:Type I cytokine receptor family, Type 4 subfamily
-
數據庫鏈接:
Most popular with customers
-
-
YWHAB Recombinant Monoclonal Antibody
Applications: ELISA, WB, IHC, IF, FC
Species Reactivity: Human, Mouse, Rat
-
Phospho-YAP1 (S127) Recombinant Monoclonal Antibody
Applications: ELISA, WB, IHC
Species Reactivity: Human
-
-
-
-
-